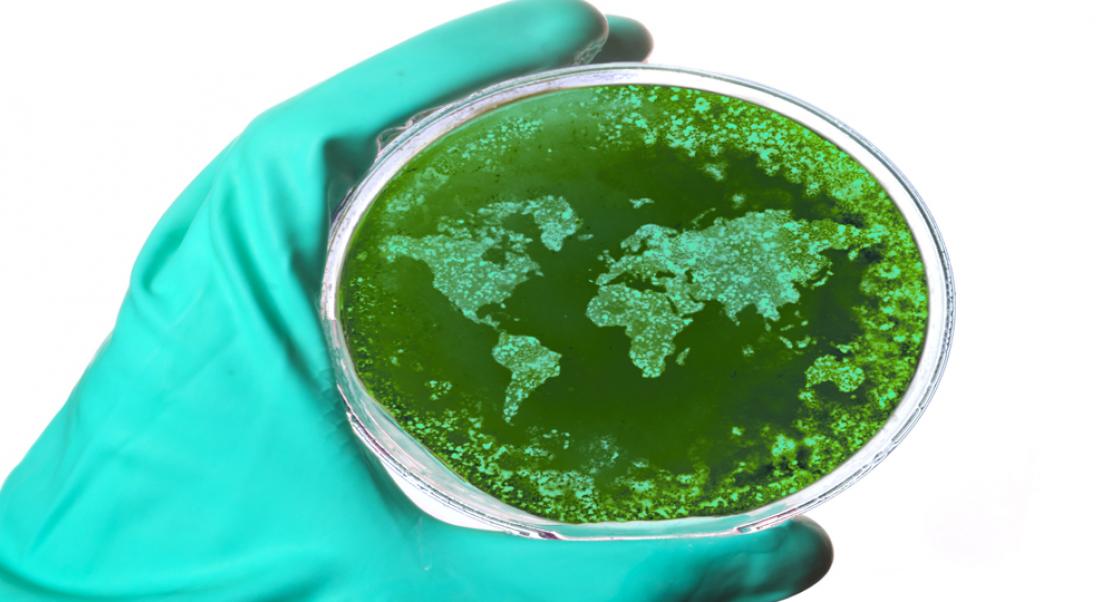
Scary Stat on Infectious Diseases (Abstract Science: Feb. 25-March 1)

Trending
|
Jillian Scola
Benefits of Fasting, New Cancer Vaccine (Abstract Science: Sept. 3 - 7)
Using DNA to identify shark bites, a new vaccine to fight aggressive cancer tumors, and can you improve health and longevity through fasting?
DNA nails source of New Yorkers’ shark bites
(Science Magazine, 9/5/2018, Elizabeth Pennisi)
Summer and sharks go hand in hand. But It’s a tourism board’s nightmare come true. In mid-July, two teenagers were bitten within minutes of each other while wading off beaches on Fire Island, a barrier island along the south shore of New York’s Long Island. Thanks to the miracle of modern science and DNA, researchers at the Florida Museum of Natural History in Gainesville were able to determine the culprit was not a great white. The match: a sand tiger shark (Carcharias taurus). This is a rare instance in which rescuers have saved shark teeth shards for further analysis; nearly 70% of bites in the attack file are unidentified.
Scientists test new cancer vaccine against melanoma
(Scripps Research, 9/6/2018)
An experimental cancer vaccine that boosts the immune system’s ability to fight cancers could work in tandem with other cancer therapies to fight aggressive tumors. Researchers demonstrated that adding a molecule called Diprovocim to a vaccine can draw cancer-fighting cells to tumor sites. Their experiments in mice with melanoma suggest these vaccines could increase chances of recovery in cases where a drug therapy alone is not working. The vaccine also prompts the immune system to fight tumor cells should they ever return, a capability that could prevent cancer recurrence.
Longer daily fasting times improve health and longevity in mice
(National Institute on Aging, 9/6/2018)
Intermittent fasting has been a trend that fitness and health enthusiasts have been talking about for years. According to a new study published in Cell Metabolism, increasing time between meals made male mice healthier overall and enabled them to live longer compared to mice who ate more frequently. The scientists randomly divided 292 male mice into two diet groups. One group received a naturally- sourced diet that was lower in purified sugars and fat, and higher in protein and fiber than the other diet. The mice in each diet group were then divided into three sub-groups based on how often they had access to food. The first group of mice had access to food around the clock. A second group of mice was fed 30 percent less calories per day than the first group. The third group was meal-fed, getting a single meal that added up to the exact number of calories as the round-the-clock group. Both the meal-fed and calorie-restricted mice learned to eat quickly when food was available, resulting in longer daily fasting periods for both groups.
---Compiled by Social Media Specialist Jillian Scola